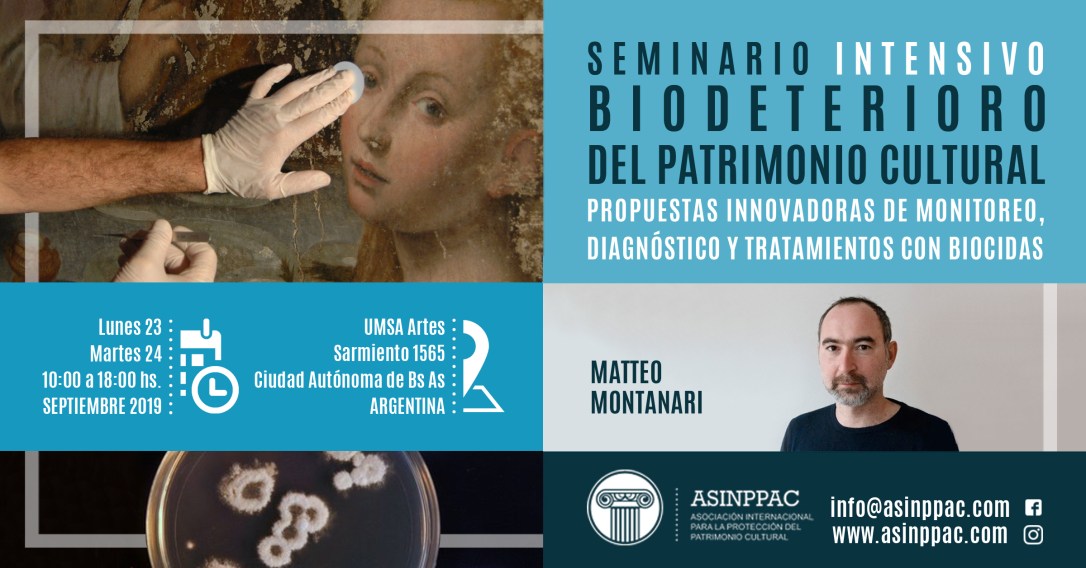
Flyer Promo Seminario MM 2019

LA MATERIALIDAD DE LOS DOCUMENTOS GRÁFICOS Y SU DESCRIPCIÓN
Docente: Diná Marques Pereira Araújo, Brasil
Lugar: Alicia Moreau de Justo 1300, UCA, CABA
Días y horarios: Lunes 23 y martes 24 de septiembre de 2019 de 10 a 18 hs.
Programa: Princípios Descripción Bibliográfica
Inscripción: Formulario
Arancel de inscripción:seminario intensivo. Dina Araujo 2019
ANÁLISIS CIENTÍFICO DE OBRAS PARA DETERMINAR NATURALEZA DE MATERIALES Y TÉCNICA DE EJECUCIÓN
Docente: David Juanes BARBER, España
Lugar: INTI, Av.General Paz 5445, CABA
Días y horarios: Lunes 23 y martes 24 de septiembre de 2019 de 10 a 18 hs.
Programa: programa Análisis científico de obras
Inscripción: formulario
Arancel de inscripción: seminarios intensivos. aranceles 2019
METODOLOGÍA Y PROCEDIMIENTOS DE LIMPIEZA Y CONSOLIDACIÓN DE OBRAS TEXTILES HISTÓRICAS
Docente: María Gertrudis JAÉN SÁNCHEZ, España
Lugar: Moreno 350, Museo Etnográfico, CABA
Días y horarios: Lunes 23 y martes 24 de septiembre de 2019 de 10 a 18 hs.
Programa: Seminario textiles_limpieza consolidación
Inscripción: Formulario
Arancel de inscripción: seminarios intensivos. aranceles 2019

EL PERGAMINO DESDE LA FABRICACIÓN HASTA SU PRESERVACIÓN
Docente: CHIARA ARGENTINO, Italia
Lugar: Adolfo Alsina 380, Convento de San Francisco, CABA
Días y horarios: Lunes 23 y martes 24 de septiembre de 2019 de 9 a 16:30 hs.
Programa: pergamino
Inscripción: Formulario
Arancel de inscripción: seminarios intensivos. aranceles 2019
BIODETERIORO DEL PATRIMONIO CULTURAL, PROPUESTAS INNOVADORAS DE MONITOREO, DIAGNÓSTICO Y TRATAMIENTO CON BIOCIDAS
Docente: Matteo Montanari, Italia
Lugar: Sarmiento 1565, UMSA, CABA
Días y horarios: Lunes 23 y martes 24 de septiembre de 2019 de 10 a 18.00 hs.
Programa: Biodeterioro
Inscripción: Formulario de inscripción
Arancel de inscripción: seminarios intensivos. aranceles 2019

